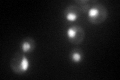
YKL145W

View description
One of six ATPases of the 19S regulatory particle of the 26S proteasome involved in the degradation of ubiquitinated substrates; required for optimal CDC20 transcription; interacts with Rpn12p and the E3 ubiquitin-protein ligase Ubr1p
Localization:
Intensity:
Fold change:
Significance:
-
C’ GFP library in SD
nucleus128.56 -
N' NOP1pr-GFP in SD

nucleus131.002 -
N' TEF2pr-mCherry in SD

nucleus83.3979 -
N' NATIVEpr-GFP in SD

punctate,nucleus131.068 -
N' TEF2pr-VC and Cyto-VN in SD

nucleus41.7342 -
C’ GFP library in SD+DTT

nucleus140.721.09No -
C’ GFP library in SD+H2O2

nucleus150.441.17No -
C’ GFP library in Starvation Media

nucleus94.010.73No -
C’ GFP library on the background of Pup2-DaMP

nucleus -
C’ GFP library on the background of CCT mutant

nucleus161.9211.25938No
